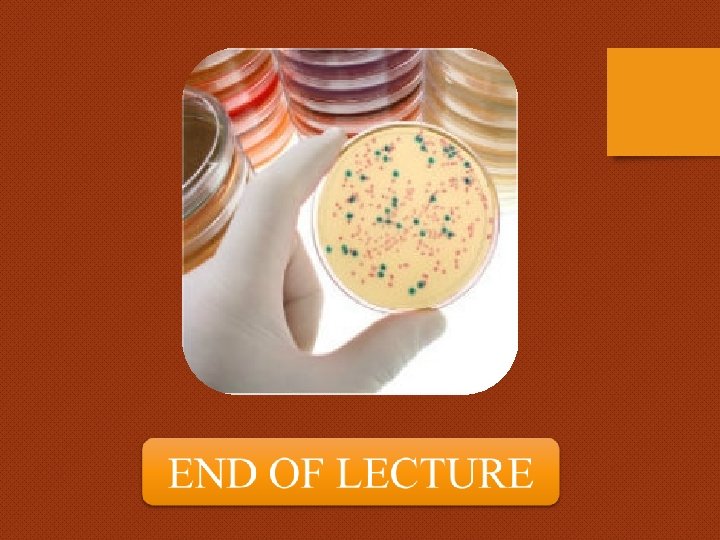

What is a Stain v A stain is

- Slides: 22
What is a Stain v. A stain is a substance that adheres to a cell, giving the cell color. v. The presence of color gives the cells significant contrast so are much more visible. v. Different stains have different affinities for different organisms, or different parts of organisms v. They are used to differentiate different types of organisms or to view specific parts of organisms
Why we should be Stain Bacteria v. In our laboratory, bacterial morphology (form and structure) may be examined in two ways: 1) by observing living unstained organisms (wet mount). 2) by observing killed stained organisms. v. Besides being very small, bacteria are also almost completely transparent, colorless and featureless in their natural states. v. However, staining can make the structures of bacteria more pronounced. v. Different types of staining methods are used to make the cells and their internal structures more visible under the light microscope.
Stains Composes From: v. Stains are a mixture of chromogen and auxochrome. v. Chromogen = benzene derivative + chromophore (coloring agent) v. Auxochrome: give +ve or –ve charge to the chromogen v. The ionized stain is capable of binding to cell structures with opposite charges.
v. Basic stains are cationic; when ionized, the chromogene exhibits a positive charge. Basic stains bind to negatively charged cell structures like nucleic acids. Methylene blue, crystal violet, safranin, malachite green and carbolfuchsin are common basic stains. v. Acidic stains are anionic; when ionized, the chromogen exhibits a negative charge. Acidic stains bind to positively charged cell structures like proteins. Picric acid, eosin, India Ink and nigrosin are common acidic stains. v. Bacteria are slightly negatively charged at p. H 7. 0 § Basic dye stains bacteria § Acidic dye stains background
Types Of Staining In Microbiological Lab v. Simple stain. v. Differential Stain: (Gram stain , Acid fast Stain) v. Special stain: (Capsular stain, Endospore stain, Flagellar stain).
Morphology Of Bacteria v The basis for staining is to study the morphology and structure of bacteria. v Bacteria primarily have distinct shapes; § spherical (coccus/cooci) § rod shaped (bacillus/bacilli)
v Based on the planes of divisions seen in the organism bacteria may also have specific arrangements of the cells. § Diplococci are formed when the plane of division is vertical and the resultant two coccal cells do not completely separate from each other. § If the cells divide in the vertical plane continually and the cells do not separate it results in a chain of coccal cells called a streptococci/streptobacilli. v Other arrangements include: tetrad (4), sarcina (8), staphylococcus (irregular clusters).
Bacterial Smear Preparation v Smear is a distribution of bacterial cells on a slide for the purpose of viewing them under the microscope. v Method: 1) Aseptically a small sample of the culture is spread over a slide surface. 2) This is then allowed to air dry. 3) The next step is heat fixation to help the cells adhere to the slide surface. 4) The smear is now ready for staining.
Simple Stain (Direct stain) v. In this exercise, we will use simple stains to show the general structures of some bacteria. Usually, a single basic stain is used in the procedure. Simple stains do not usually provide any data for identification of the bacterium; they simply make the bacterium easier to see. v. To observe basic external structures of cell with bright field scope (cellular morphology)
Procedure of Test 1) Obtain broth cultures of the bacteria. 2) Using an inoculating loop, remove a loopful of suspension from one of the tubes. Remember to use sterile technique. 3) Smear the bacteria across the center of the slide with the loop. If the bacterial suspension is very thick, add a drop of water and mix the bacteria and the water on the slide. 4) Allow the smear to completely air dry. § Air dry first to prevent lysis (boiling)
5) Heat-fix the smear by quickly passing the slide through a Bunsen burner flame three times. This causes partial melting of the cell walls and membranes of the bacteria, and makes them stick to the slide. Do not overheat the slide as this will destroy the bacteria.
6) Cover the smear with a few drops of one of the stains. Allow the stain to remain for the following periods of time: • Carbolfuchsin- 15 -30 seconds. • Methylene blue- 1 -2 minutes. • Nigrosin- 20 -60 seconds. ü The stain can be poured drop by drop on the slide 7) Gently rinse the slide by holding its surface parallel to a gently flowing stream of water. 8) Gently blot the excess water from the slide with bibulous paper. Do not wipe the slide. Allow the slide to air dry. 9) Observe the slide under the microscope with air and oil lenses.